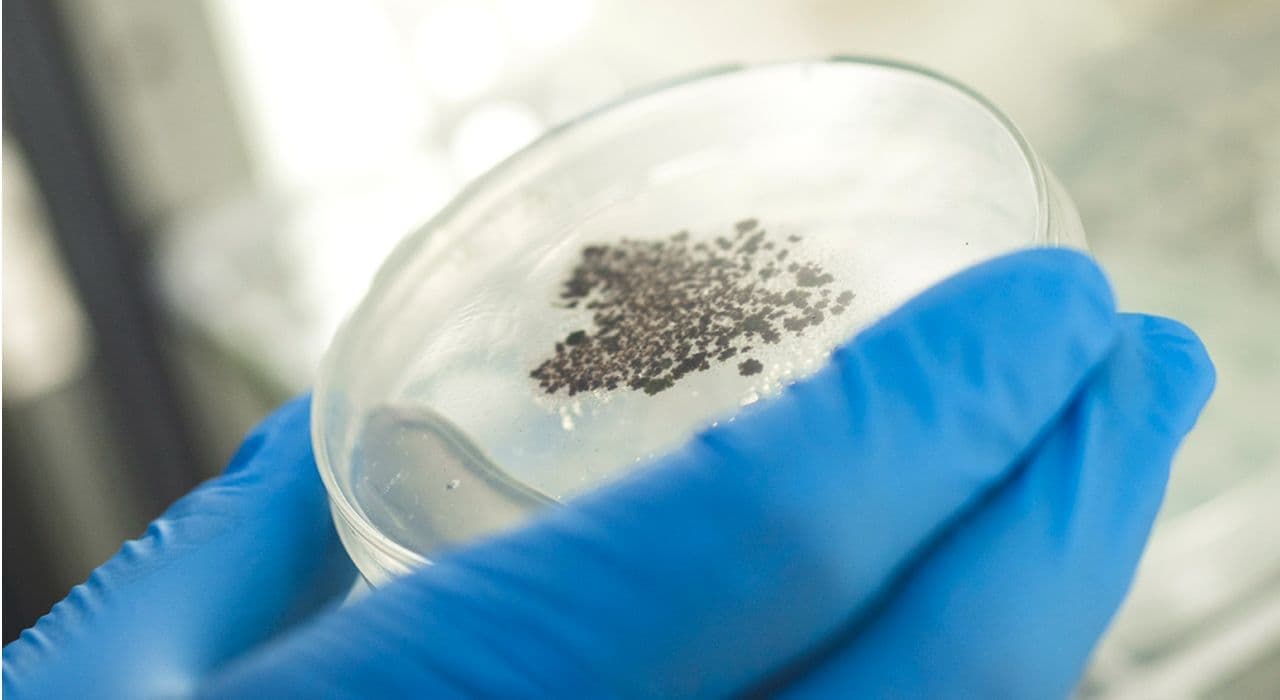

私たちは、優れた抗酸化成分として知られている「アスタキサンチン」に着目し、その原料となる微細藻類「ヘマトコッカス藻」の培養からオイル抽出までを行っています。
こだわり抜いて生み出されるアスタキサンチンは安定した品質を実現し、健康・美容分野だけでなく飼料や肥料など、多様な製品を販売しています。その高い品質と信頼性を礎に、私たちはこれからも研究開発を重ね挑戦し続けるとともに、お客様の健やかで豊かな暮らしに貢献できるパートナーとして価値ある製品とサービスをお届けします。


私たちは、優れた抗酸化成分として知られている「アスタキサンチン」に着目し、その原料となる微細藻類「ヘマトコッカス藻」の培養からオイル抽出までを行っています。
こだわり抜いて生み出されるアスタキサンチンは安定した品質を実現し、健康・美容分野だけでなく飼料や肥料など、多様な製品を販売しています。その高い品質と信頼性を礎に、私たちはこれからも研究開発を重ね挑戦し続けるとともに、お客様の健やかで豊かな暮らしに貢献できるパートナーとして価値ある製品とサービスをお届けします。